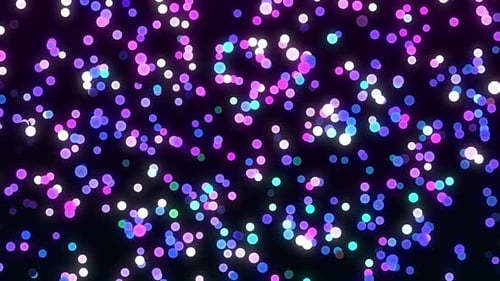
Animated Glowing Blue Purple Pink Bokeh Lights Background

Floating Blue Bokeh Particles Abstract Loop Background
By ponravinpOne great value subscription from $16.50/month
- Unlimited downloads of 27+ million creative assets
- AI Tools: video, image and more
- Lifetime commercial license
- Easy cancellation
Already have an account? Sign in
Attributes
- Length
- 0:20
- Resolution
- 3840 x 2160
- File Size
- 178 MB
- Frame Rate
- 29.97 fps
- Alpha Channel
- No
- Looped
- No
- Video Encoding
- H.264
- Orientation
- Horizontal
- Commercial License
- Further Information
Description
This animated background features a mesmerizing display of soft, glowing blue and white bokeh particles. The gentle, upward movement of various-sized light orbs creates an ethereal and dreamy atmosphere. These abstract lights appear to float and subtly fade in and out, adding a magical touch against a deep blue gradient backdrop. Designed for seamless looping, this versatile visual can enhance intros, outros, presentations, or serve as an atmospheric overlay for various video projects, creating a sense of wonder and calm.